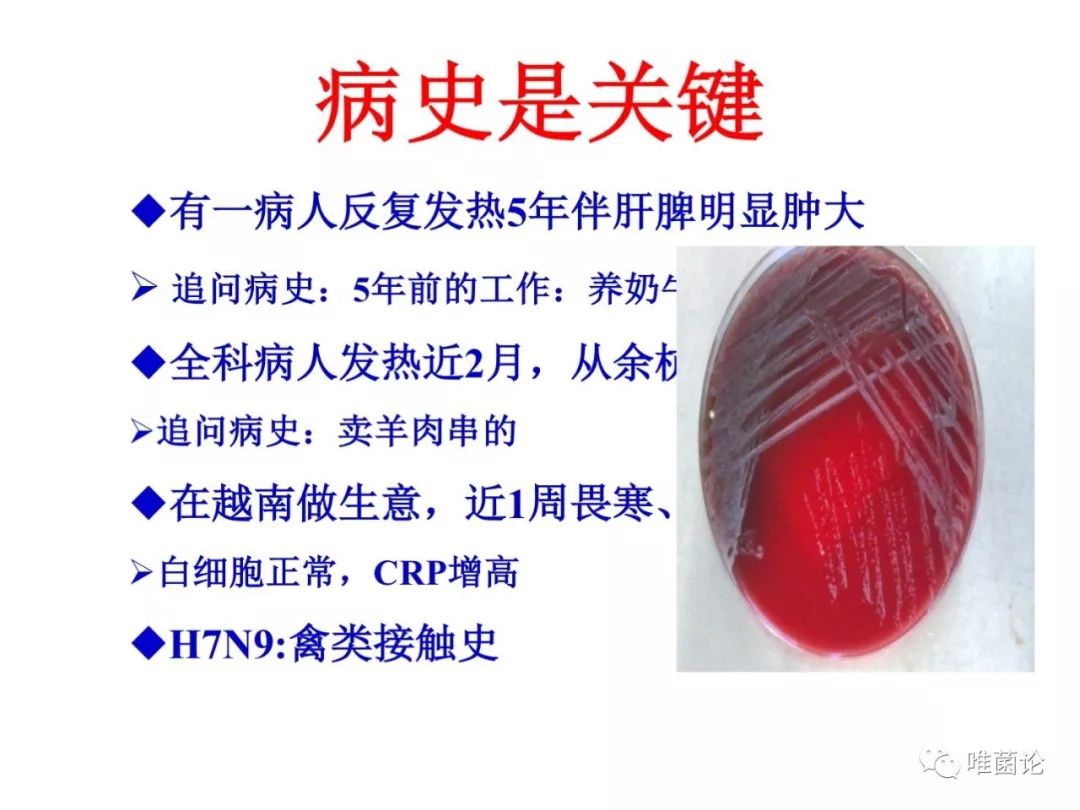

2019年10月13日,华大基因联合唯菌论推出的“唯菌计划”病原精准诊疗研讨会第一站在杭州成功举行。会上临床教授,检验专家和研发团队,分别从各个领域探讨了宏基因测序(mNGS)技术在感染病诊疗领域的应用。
今天,小菌将和大家分享俞云松院长有关于“感染性疾病诊治策略”的报告。
俞云松
浙江大学医学院附属邵逸夫医院副院长,感染科主任,教授,博士研究生导师
声明:
1、凡本网注明“来源:小桔灯网”的所有作品,均为本网合法拥有版权或有权使用的作品,转载需联系授权。
2、凡本网注明“来源:XXX(非小桔灯网)”的作品,均转载自其它媒体,转载目的在于传递更多信息,并不代表本网赞同其观点和对其真实性负责。其版权归原作者所有,如有侵权请联系删除。
3、所有再转载者需自行获得原作者授权并注明来源。
最新评论
相关分类
关闭 官方推荐
 /3
/3

浙公网安备33010802005999号
浙公网安备33010802005999号


